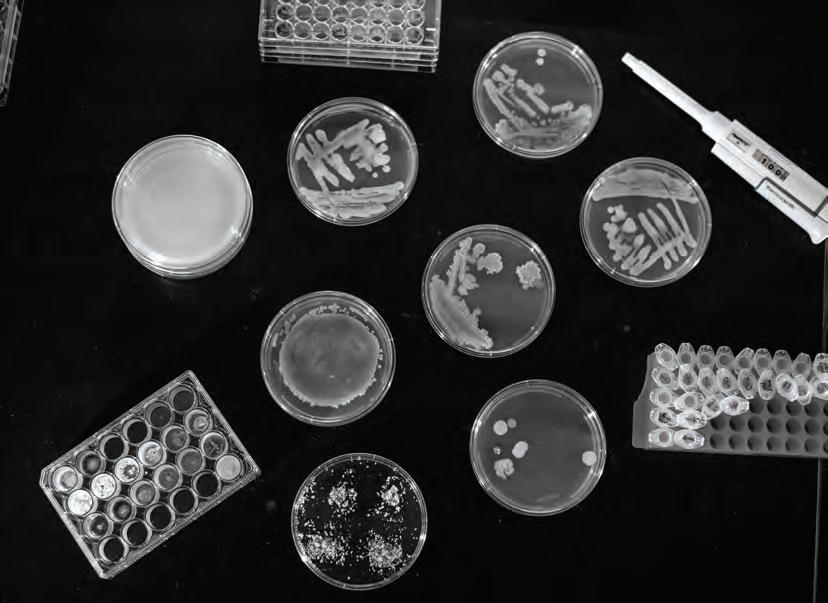

Welcome to the second western issue of SYNKD. We have been busy this fall traveling to conferences to see the new products and technologies driving innovation in landscaping. The SYNKD team attended the ELEVATE conference in Florida and Equip Expo and Hardscape North America in Kentucky— which were both amazing. We made so many connections and saw so much enthusiasm for our industry.

has affected your business and how you are learning to move forward. We catch up with radio and television personality Nick Federoff to learn how he got started and how he is making an impact on the industry through broadcast media and his involvement with the Green Industry Hall of Fame.
Jay Worth shares how to improve employee retention to save your company time and money. Columnist Deborah Cole explores how burnout in the workforce can cause safety issues in the field.
The founder of Towa Tools explains the need for innovative solutions in the gas-to-electric movement, including charging infrastructures that can power a fleet safely.

We share projects to inspire you to take your client spaces to the next level by working with natural elements and the environment to create outdoor havens with minimal maintenance.
OWNER/MANAGING DIRECTOR
Angelique Robb angelique@synkd.io
ADVERTISING & TRADE SHOW COORDINATOR Aimee Almaguer aimee@synkd.io
EDITOR Cindy Whitt cindy@synkd.io

GRAPHIC DESIGNER
Caitlyn Wallace caitlyn@synkd.io
SUBEDITOR Erin Z. Bass
Anne Marie Fruge annemarie@synkd.io
I just returned from the ASLA Conference on Landscape Architecture in San Francisco, where I talked with companies launching new practices to change the way we think about traditional landscape architecture.
It is so exciting to attend these industry conferences and tell industry members about our mission to bring the design + build + maintain sectors together in one publication and one yearly event. It’s great to hear how many professionals really believe in what we are bringing to the industry.
In this issue, we talk about how the past year
We also follow up on a previous education piece from Coldspring USA with information on installing natural stone pavers to last by starting with intentional design and building with the end in mind.
We are gearing up for SYNKD LIVE, our education conference and expo to be held February 6–7, 2023, in Atlanta, Georgia. Tickets are on sale now. Visit www.synkd.io/live-event for a list of speakers.






323 Polk Street Lafayette, Louisiana 70501



OWNER/MANAGING DIRECTOR
Angelique Robb angelique@synkd.io (337)247–9497
ADVERTISING & TRADE SHOW COORDINATOR Aimee Almaguer aimee@synkd.io (337) 247–9337
EDITOR Cindy Whitt cindy@synkd.io

GRAPHIC DESIGNER
Caitlyn Wallace caitlyn@synkd.io
SUBEDITOR Erin Z. Bass PRINTED BY Allen Press Inc. www.allenpress.com Published by © SYNKD
SOCIAL MEDIA/MARKETING Anne Marie Fruge annemarie@synkd.io

SYNKD is published six times a year and distributed to 5,000 qualified members of the green industry. Postmaster: Send address changes to 323 Polk St., Lafayette, LA 70501. SYNKD verifies information as much as possible. The views expressed by editorial contributors and the products advertised herein are not necessarily endorsements of the publishers. Reproduction of any part of this magazine is strictly forbidden.
22
Nate Dodge is the owner of ND Design Services Inc. As a landscape designer and visual artist, Nate’s mission is to offer client-focused solutions and translate design through refined graphics and land art. He has hands-on experience in many facets of the industry, including fine landscaping, commercial landscape maintenance, commercial and residential design/build, landscape architecture and landscape design.
www.nddesignservices.net
As the founder and president of a commercial landscape firm with multiple locations throughout Texas, Deborah Cole has learned the importance of a peoplecentric leadership and communication. She now devotes herself full time to speaking, writing and consulting with a heavy dose of visual storytelling (photography) included.

www.deborahcoleconnections.com
Share an opinion or helpful tips and insights that you have learned in the industry.
Each issue poses a different question that you have an opportunity to answer.
Answer some fun questions that allow the audience to get to know you better.
Share a recent project that you and your company have been working on!
Mark Carlson is the founder of the Experiential Landscape Lighting Initiative (ELLI), an educational resource dedicated to the landscape lighting profession. He has 22 years of experience as a landscape lighting designer. He is currently performing studies on the psychology of light and nature to provide therapeutic relief in human health. He is also the owner of Avalon Lighting Design.

www.landscapelightinginitiative.org



Jay Worth is the marketing manager for SingleOps, which specializes in business management software for the industry. He brings to them over 20 years of experience in green businesses. He has done sales and marketing and supervised teams and now shares his knowledge widely in editorials.
www.singleops.com
For additional information on ways to be involved with SYNKD, please visit our webiste www.synkd.io or scan the QR code below!



STIHL Inc. announced the winners of the 20222 Hearts of STIHL program, an initiative to care for the environment through the preservation of US. state parks. The awarded grants will be managed by America’s State Parks Foundation, ensuring that all funding will support environmental efforts and educational progr amming. More than 25 parks applied for the grant, with a broad variety of funding and support needs.

The recipients of the Hearts of STIHL grants include parks in Alabama, Tex as and Kentucky. The program expands STIHL’s relationship with Ameri ca’s State Parks. For more than a decade, STIHL has been a sponsor of the National Association of State Park Directors Leadership School, providing scholarships for park personnel to attend. stihlusa.com/community/hearts-of-stihl
Giving back to military veterans, five members of Boulder Parks and Recreation’s Forestry team pruned branches and removed trees at Fort Logan National Cemetery in Boulder, Colorado, this fall as a part of the Saluting Branches event.

Saluting Branches gives the tree care and landscape industry the chance to show its support for our troops by helping to make their final resting places a safe and beautiful environment for all who visit. This was the seventh year the city of Boulder participated in the national event.
“This is a great opportunity for us to give back to our community,” says Forester Michelle Ferguson. “We work throughout the day in one area of the cemetery and prune or remove ash and spruce trees. Fort Logan has a minimal number of forestry employees on staff, so this event helps keep the grounds looking nice for everyone.” salutingbranches.org

The California Air Resources Board announced a new funding category offered through its Clean Off-Road Equipment Voucher Incentive Project (CORE), which will make point-of-sale discoun t vouchers available for zero-emission professional landscape service equipment. This new funding category, administered by C ALSTART, has an allocation of over $27 million of voucher funds for elig ible professional landscape services operated by small businesses or sole proprietors. CORE began accepting vouchers on November 7, 2022. californiacore.org/how-to-participate-professional-landscape

The inductees of the 2022 Green Industry Hall of Fame were announced this fall. The individuals nominated have made a significant impact or positive influence that assures the future of our industry in the lives of generations to come.

Once nominated, inductees are placed in the polls for voting. At the end of the year, the committee takes into consideration the votes and decides which candidates are inducted. The 2022 inductees are Perry Cardoza, David Cox, Richard Greenland, Janet Hartin, Steve List, Tim Nord, Victoria Phillipy, Katharine Rudnyk and Phil Steinhauer. greenindustryhalloffame.org/inductees
Equip Exposition set a new attendee record, welcoming more than 25,000 attendees and exhibitors to the October event in Louisville, Kentucky. This year’s show debuted a new brand and new experiences for its participants. Expo attendees hailed from all 50 states and 49 countries, with the furthest traveling attendees journeying from Guam, New Zealand and Australia. Next year’s show at the Kentucky Exposition Center will be held October 18–20, 2023. equipexposition.com
The National Association of Landscape Professionals (NALP) released its 2022 Compensation & Benefits Report, which provides compensation and benefitsrelated statistics for landscape and lawn care companies.This report is presented in partnership with Aspire and is compiled from responses from 180 companies in more than 400 locations.
The report includes data on recruiting and retention, health care costs/trends, retirement benefits, PTO and other leave, and sales practices. The 2022 Compensation & Benefits Report costs $399 or $199 for NALP members. landscapeprofessionals.org/store
Owner and Chief Designer of WaterWise Landscapes, Inc. Albuquerque, New Mexico


Our biggest issue through the whole pandemic has been manpower. Finding work has not been the problem—we’re booked out to next summer. We work really hard to keep our people happy, so we have raised our wages.

CEO of TOWA Industries, Inc. Campbell, California
Our greatest challenge in 2022 was being able to adapt and change our business model to compensate for supply chain issues and for when big manufacturers pulled off the California market because of the new CARB standards. This put us and a majority of the outdoor power equipment dealers in a hard spot to try and keep up with the increasing demand for battery and short supply.
Director of Water Management of Park West Companies Rancho Santa Margarita, California
Our biggest challenge in 2022 was the transitioning of our smart controllers from 3G to 4GLTE cellular modems, due to the 3G network being shut down by the major carriers. Not only did we have to navigate supply chain issues, but our clients were not ready for this unforeseen expense. This challenge was conquered through proper planning, education and dozens of HOA board meetings.











Nick Federoff likes to talk about landscaping and gardening, so he made it a career. After several years of working as a landscaper, he discovered a passion for public speaking when he filled in for a host on a gardening radio show in southern California.
“I figured that was going to be my 15 minutes of fame, and I was going live on that forever,” he says.
That hosting gig was in 1986.
Nick’s 15 minutes of fame is still going strong after 36 years, and he is still as passionate
about it as when he began. He hosts “Nick Federoff on Gardening,” a two-hour, call-in radio show that airs nationwide every weekend. “Things Green Garden Minute” is his daily, 90-second, award-winning program packed with lots of information in a small amount of time.

In addition, Nick is the resident on-air garden expert for the local CBS Los Angeles news station segment “In the Garden.” He also hosts a weekly, 30-minute television show called “Things Green,” broadcasting on PBS|KLCS Los Angeles.
The radio audience loved him from his first day on air, and the station program
director called him into the office soon after his debut.
“I figured I killed some old lady’s posies, and I was in trouble,” he says. “I walk in, and the program director gives me a big ‘ole bucket of mail and says, ‘You generated more mail in one two-hour show than the (previous host) has done for the last couple of years.’”
Nick resonated with audiences right away because of his storytelling style. Talking about plants and landscapes without a visual can be difficult, but he says his vivid descriptions inform audiences without being patronizing to people in the business and seasoned gardeners.
“There is a fine line there, but I think that’s one of the successes I’ve been blessed with,” he says. “Plus, I don’t know how to shut up.”
Like many landscapers, Nick got his start mowing lawns. From there, he learned about gardening and built a residential landscaping service. An incident with a potential client may have changed his trajectory.
“I went to one lady’s house, and she had, hands down, the most beautiful yard I have ever been in,” he says. “I gave her a bid, and she looked at it and said, ‘Get off my property. You’re nothing but a lawn boy.’”
So, he went to college to get a degree in ornamental horticulture and learn everything he could about the industry.
Nick later partnered with his father and brother to build a commercial real estate construction business with a landscape installation and weed abatement branch. The firm became the largest weed abatement contractor in the area, with crews working day and night.
He managed the company’s contracts with municipalities and large corporations in southern California. He also worked on his public speaking chops at various industry events.
One of the corporations where they had contracts employed a consultant who was also the host of a gardening radio show. His boss saw Nick in action and asked if he would like to fill in for the consultant. The rest is history.
Since 1995, Nick’s radio show is broadcast across the country on 250 affiliates, so his audience comes from areas spanning the U.S., not just in his southern California location.
“One of the questions I get from radio station program directors is ‘how do you know what’s going on with the plants in our area?’ I live within a two-hour radius of every growing zone in the U.S.,” he explains.

Because of his location, Nick has experience with various growing zones and can answer questions about any area on the USDA Plant Hardiness Zone Map. His audience includes people new to gardening who want to know why their tomatoes are dying to landscape professionals needing help finding the right equipment.

With more than 2,500 radio shows under his belt, he has answered thousands of questions and helped with some unique situations, including a call he had from a woman with an unusual problem.
The woman told Nick she had mushrooms growing in her car. His first thought was what kind of passengers do you have?
“What we figured out was that she likes mushrooms,” he says. “She buys mushrooms (from the farmers market), but they fell out of the bag. When it rained, the water leaked through her windowsill and mushrooms started to grow from the ones left behind in her car.”
In 2012, Nick was inducted into the Green Industry Hall of Fame, an award developed in 2005 to honor people who have made significant contributions to the industry. To qualify, inductees need a minimum of 20 years in the industry and must provide education and encouragement to others. He was the first radio and television personality to receive the honor.



Nick later joined the board of directors and was involved with the annual dinner honoring inductees. During the COVID lockdown, the board was going to cancel the 2020 dinner, but Nick did not want that year’s inductees to miss out, so he organized a live broadcast from the Sherman Library & Gardens in Corona Del Mar as part of his “Things Green” PBS show. The outdoor event allowed the inductees to be honored in a safe setting with prerecorded clips from others who could not travel.
“I don’t like doing the same thing over and over,” he says. “Last year, instead of doing a 30-minute show, we took each person inducted and put a bit of their award ceremony into the last three minutes of
(my TV) show. So, every single week for 26 weeks, the Green Industry Hall of Fame is on people’s minds.”
Nick has recently traveled to industry trade shows to meet inductees and share their achievements on social media.
“This year, I’m not sure what we’ll do, but it’ll be the best yet,” he promises.
Connecting the Sectors
Nick is always learning, and part of his education is visiting trade shows for various industries. He sees the value in attending to connect landscaping to other sectors, like a recent architecture expo where he learned how architects view landscapes from the perspective of their buildings.

“There were so many things there that are complementary to the world of landscape design and the architecture that they do— from the type of building, the reflection of the windows on the landscape, to what you’re going to use for a walkway and how you’re going to take the people through that pathway,” he says.
Nick tries to keep his pulse on change in the industry so that he can be a resource for people.
“It’s my job to find these things out, and that’s why I have an open door for any landscaper because they don’t have the time to go to those shows,” he says. “There’s got to be communication
between the landscaper, the architect, the nursery and the suppliers. That’s why it’s important (for me) to do all these shows. This way, you’re staying fresh and getting information, which benefits the client.”
1 Nick is host to a weekly 2-hour syndicated radio show and a daily 90 second short form program
2 Nick on a road trip to Southland Sod Farms to discuss how sod is grown
3 Expert Horticulturalist Nick Federoff “In the Garden” showing Meteorologist Alex Biston how to grow vegetable seedlings on CBS|KCAL 9 News
4 Nick giving a public presentation at his 911 Mobile Memory Garden
5 Nick stops in at the Chapin International booth from trade show to get the latest in sprayer technology
6 Nick showing off a couple of numerous Telly Awards for his weekly PBS TV show, Things Green
7 “Lights. Camera. Action!” Nick produces and hosts The Green Industry Hall of Fame Awards Show

Phone: (800) 405–NICK www.thingsgreen.com
“Things Green” show on PBS 9 a.m. Saturdays on KLCS-TV 58 or online at www.youtube.com/c/ ThingsGreenwithNickFederoff
“In the Garden” on CBS|KCAL 9 News Los Angeles 8 a.m. Saturdays www.cbsnews.com/losangeles/live
“Nick Federoff on Gardening” radio show 8 a.m. Saturdays PT/11 p.m. ET
Check local listing for a radio station near you or online at www.adrenalineradio.com/nfog.html
Eight percent of the world’s carbon emissions come from one source. It accounts for more carbon emissions than every country on the planet, apart from the United States and China, and exceeds the carbon emissions of 170 million cars. The culprit? Cement. It is in our homes and is spread throughout our communities. Concrete, the key component of cement, is the second-most consumed substance on Earth after water.
Portland cement has been industrially produced since the early 1800s. Producers combine a mix of mined materials, largely crushed limestone, and heat them to high temperatures (roughly 1400°C). The heat drives a reaction, leaving behind calcium oxide, which then reacts with silicates to form cement. During that time, large amounts of carbon dioxide are released into the environment through calcination and fossil fuel combustion.
Biomason offers an alternative to portland cement called Biocement. This




technology uses carbon as a building block, combining it with calcium to create microbiologically formed mineral cement within concrete products at ambient temperatures. The patented process eliminates the need for cement kilns and calcination emissions by mimicking how calcium carbonate—a material commonly found in eggshells, coral, seashells and limestone—grows in nature, harnessing carbon rather than emitting it as a byproduct. Biomason uses biotechnology to recreate this natural process in less than 72 hours, and its Biocement products meet or exceed standard material performances, including compressive strength testing.


Cofounder and CEO Ginger Krieg Dosier was inspired by marine structures like shells and coral during early childhood trips to the beach. She was fascinated by how these structures were grown, and later pursuits in her discipline in architecture and academia probed a deeper investigation to uncover if we could produce cement similar to how natural marine structures are made.

Dosier incorporated Biomason in 2012 and has since built a team representing more than 50 disciplines to accelerate Biocement’s global expansion. Biomason recently partnered with Denmark’s largest concrete producer, IBF, to launch commercial-scale manufacturing, with production starting in April 2023. The company also works with the U.S. Department of Defense on developing novel applications of Biocement technology.

Biomason describes its technology as proactive rather than reactive. Instead of working to limit the impact of traditional cement production, Biomason created a new process altogether. They plan to continue scaling the Biocement technology platform and growing licensing partnerships worldwide to remove 25 percent of carbon emissions from the global concrete industry by 2030.






Owner, Boxhill & Co. Marana, Arizona www.bklandscapedesign.com shopboxhill.com
Landscape Designer, BK Landscape Design Petaluma, California

What inspired you to get into the industry?
Growing up being in the outdoors, camping, scouting and always being curious about what everything does in nature.
What’s your favorite place you’ve ever visited?
I loved the natural beauty and lifestyle of those in Switzerland and the Lauterbrunen area. Seeing Versailles after so many years in studies and in imagery was amazing.
What would you blow your money on? Vacations and .09 pencil lead.
What’s the biggest challenge you’ve faced professionally? Unrealistic or unreasonable expectations.
What’s the one thing that would make the industry better?
A better collaborative understanding of build costs between client, designer and contractors.
MiniWhat’s the key to great design?
Understanding the needs and wants of the client and relating elements to the existing architecture, site features and natural surroundings. If it feels natural and not designed, then it’s good design.
What inspired you to get into the industry?
My love for outdoor spaces and plants. I could of easily gone into architecture, but I loved plants so much. It’s so nice to work with material that grows and changes, plus I get to be outside.
What’s the biggest challenge you’ve faced professionally?
Rapid growth during Covid. Yes, it is a blessing to grow 457 percent, but it was still a problem. We struggled getting the right staff and all the growing pains that come with more employees.
What is your favorite phrase, slogan?
“Buy once, cry once.” I prefer quality over quantity every single time.
What is something not many people know about you?
I am Lebanese.
What’s the best advice you have received for your career?
“Nobody knows your list.” Someone once told me this, because I was getting ready to shoot a garden and I was walking around being very critical, and a person said this to me, and it was such good advice. What I can see as not being perfect, the average person doesn’t even notice. I tend to be my hardest critic.
Principal, Spring Greenworks Kirkland, Washington
Owner/General Manager, Gary Krause Landscaping and Design Jacksonville, Oregon garykrauselandscaping.com www.springgreenworks.com

What’s your favorite place you’ve ever visited? Naxos, Greece
What’s the one thing that would make the industry better?
More lobbying for environmental changes, including recycling materials and eliminating toxic products.
Who do you most admire in the industry? Piet Oudolf and James Van Sweden
What’s your ideal Saturday? Walking the dog to the beach, a core workout class and reinventing part of my garden.

What advice would you give to someone entering the green industry? Join as many trade organizations to connect with your peers and colleagues.
What is your favorite karaoke song? “September” by Earth, Wind & Fire
What’s the key to great design? Follow the masters of your field, visit gardens worldwide and follow the principles of good design.
What is something not many people know about you?
I am obsessed with shells and beach artifacts.
What’s the best part of your job? To see what we have created for our clients and the compliments we get for our work.
What’s the biggest challenge you’ve faced professionally? Getting through the 2008 recession.
What’s your best childhood memory? Growing my first garden with my granddaddy.
What three items would you take with you on a deserted island? My dog Luna, a pocket knife and a pocket water filter.
What is your favorite phrase, slogan? “It’s not how much experience you have in life, it’s more about how much life you experience.”
What’s the best advice you have received for your career? Charge for estimates and design consultation.
What’s your favorite place you’ve ever visited?
The Applegate Valley in Oregon
What would you blow your money on? More advanced technology
Owners and stakeholders want their properties to look their best. The landscape creates a first impression for the community and surrounding market. When residential properties, HOAs, commercial centers and office parks utilize site enhancement programming, they experience more efficient and aesthetic grounds. The results positively affect both owner and contractor. As a landscape maintenance company, your work follows you. Curb appeal communicates quality and company values. Be proactive. Show your clients through each season how small changes and improvements yield big results.
You don’t need to start over. Utilize the property’s existing strengths and work with them. If a specimen offers contrast with a building, keep it, manicure it, reshape it and work with what is already there. Remember, architecture comes first. The landscape should support and complement the architecture. Do not clutter the foundation of a nice building with trees and plantings. Clutter is a waste of maintenance and resources. Instead, focus, accent and reshape to save money.
Plant with the future in mind. We need to be thinking at least 10 years ahead. Trees are powerful. It is sad every time a large
tree comes down because it overgrew its space, covered over a building or damaged a foundation. Plant smart— know your trees and their growth habits. Utilize dwarf shrub varieties for less pruning and safety. Big shrubs covering entryways and windows create an opportunity for crime and theft, which leads to unhappy clients and lost maintenance contracts. Shrubs and trees that don’t overgrow the space require less money and maintenance. Contractors win when clients are happy and save money.
create impact. Utilize plant height using terrace beds with different plant sizes, such as groundcovers, dwarf grasses and smaller evergreen shrubs. Combine this with taller accent shrubs that offer a backdrop with multiple seasons of color and interest. High-impact planting is strategic, creates a focal point and ensures aesthetic value.

There is no dormant season for an entryway trying to attract business. Entrances make the initial impression upon residents, clients and customers. These areas need to be safe, clean and aesthetic. It is achievable no matter the budget. Embrace regular cleanups and pruning. Adorn entryways with swappable annuals and seasonal displays year-round. Consider a well-placed planter or two that match the building’s façade or signage when bed space is limited. An aesthetic entryway that is warm and welcoming matters most.
Embrace the “wow” factor. Annual flowers provide a dynamic pop of color for every season. Do not be afraid of symmetry. There are moments to embrace formality for a sense of organization in the built environment. Consider bloom times and spread things out so there is ornamental activity all year. Masses of single variety plants are noticeable from a distance and

ND Design Services, Inc. Email: ndodge2@gmail.com Phone: (267) 678–7507
Job burnout is a unique type of workrelated stress—a state of prolonged emotional, physical and emotional exhaustion that might also include a sense of reduced accomplishment and loss of personal identity. Burnout occurs when you (or an employee) feel overwhelmed, emotionally drained and unable to meet constant demands on the job.

We know it is possible to have some of these feelings on any given day in our challenging jobs in the green industry. Who hasn’t felt physically exhausted after long weeks of relentless heat or cold weather with too much work to do and not enough materials to accomplish it? And who hasn’t wanted to run for the hills after being disrespected one more time by a disgruntled customer who can’t get things done to his/her satisfaction? How about when the family situation at home has been less than ideal over a weekend and you arrive at work Monday morning to a work area stacked with too much
work and too few people to accomplish it? Had enough? Then you are not alone. It happens to all of us no matter how much we love our industry or how much we love our jobs. But if there is never any sign of relief, the unthinkable can happen.
If burnout isn’t something personally felt, you might have witnessed it in others in its most profound manifestation. Direct reports who were once very enthusiastic over time have become unproductive to the point of apathy. Where they were once eager and receptive, they are now cynical and critical. Have you observed increased absenteeism and less enthusiasm to take on new tasks? Is praise no longer met with gratitude and smiles and nothing on the job ever seems to go right? Have you wondered what has set the cycle in motion?
In reality, it’s often not the job or the workload per se, but the outcome is the same. Stress, disillusionment and dissatisfaction become common states of being. And burnout can lead to less focus as well as accidents and safety issues on the job.This can occur whether or not the position involves machinery, equipment, vehicles or office tasks. Do you notice in yourself or your direct reports any of the following:
• Serious errors in judgment while on the job
• Inability to get a restful sleep resulting in foggy head on the job
• Sadness, anger or irritability that leads to inability to get along with coworkers
• Alcohol or substance misuse on the job or residual effects from either on the job
• Personal long-term health issues, including heart disease, high blood pressure, type 2 diabetes, vulnerability to illnesses
It is critical to take action when burnout is experienced personally or observed in others. There may be options to eliminate or change work situations as well as to seek medical or therapeutic support. At a minimum, it is helpful to explore activities for stress relief outside of work. Ignoring the facts and hoping that things will improve without addressing the issues can lead to accidents, which are waiting to happen.
Deborah Cole is the founder of a commercial landscape firm with multiple locations throughout Texas. She now devotes herself full-time to speaking, writing and consulting. www.deborahcoleconnections.com














Location: Albuquerque, New Mexico Build Time

2–3 weeks for landscape, irrigation & cistern Size: About 1,000 sq. ft.
Hunter Ten Broeck is leading the way in smart water solutions and natural landscapes in Albuquerque, New Mexico. Aptly named, his firm WaterWise handles design, build and maintenance with a specialty in irrigation and drought-tolerant plants. He and his wife founded the company in 1993, as the region was just starting to mandate water-use restrictions.
“In the ‘70s, ‘80s and ‘90s, the area experienced a record-breaking wet period,” recalls Hunter.
During this time, residents lived as if they had an unlimited water supply, but studies indicated Albuquerque was using its groundwater reserves—fed by the Rio Grande—nearly three times faster than it could be replenished. Per capita daily water consumption was at 250 gallons, while today it’s dropped to around 125 gallons.
“At first, when we talked about water conservation, what I did was a little more of a hard sell,” says Hunter. “Clients were used to their green lawns and high-water plants.”
At an elevation of 5,000 feet above sea level, Albuquerque is located on the northern section of the Chihuahuan Desert. Adding to the dry climate is a “mega-drought,” which Hunter says has been going on for more than two decades.
But just because water is scarce doesn’t mean Hunter’s landscapes are dull and bleak. In fact, they’re quite the opposite. The thriving landscaping at the WaterWise office has become an example to clients and a lead generator for people driving by. Rising above flourishing plants in bright purple, red and yellow is a giant metal cistern which supplies water to the property year-round.
“After renting for a while, we bought our building in 2013. As part of our remodel, we planned the cistern so all the water could come off the roof to one place,” says Hunter.
The cistern can hold 1,800 gallons of water and in nine years, WaterWise has only had to fill it manually three times. One inch of rainwater collected on a 1,000-square-foot property equates to 600 gallons of water. So, an inch of rainfall on the 3,100-square-foot roof at the WaterWise office can supply the entire cistern.


“We’ve discovered some plants that will flower right through winter, which is unusual, like the Angelita daisy,” he says. “We try to plan so there’s color in every season and it’s not just the same all year.”
Hunter also likes to incorporate plants that attract wildlife, like Vermilion Bluffs Mexican Sage for hummingbirds and Lynn’s Legacy Texas Ranger for bees. “Albuquerque is home to an urban wildlife refuge, and more and more clients are requesting plants that attract pollinators,” he says.
Around the WaterWise office is a fence that’s both beautiful and functional. The base is made from rough-cut cedar and the top is wrought-iron. Gabions along the fence, made from recycled materials, serve as an interesting architectural feature as well as for erosion control.


For the patio, WaterWise installed regionally sourced flagstone. Hunter steers away from gravel patios because of the heat; however, he likes Crusher fines,
According to Hunter, more than half of Albuquerque’s annual rainfall of 13 inches occurs between July and October, which they can store for the drier months ahead. The cistern runs on an automated drip system and when it overflows, water is diverted through a French drain to secondary plantings that line the parking lot.
“The water in the cistern also moderates the temperature, which is warmer than the air in winter and cooler than the air in summer, allowing us to plant different things than we normally would,” says Hunter. “Albuquerque is in Zone 7b and has extreme temperatures, creating microclimates around the area. In the winter, it can drop below freezing, while in the summer temperatures can reach 100 degrees.”
Hunter likes using his office garden to experiment with different plants he’s not as familiar with.
angular bits of gravel, to create informal walkways and also uses gravel mulch around plants. Hunter also prefers not to use artificial turf. “My own personal preference is to be surrounded by green living things,” he explains.
Over the years, Hunter has been featured in numerous publications and on podcasts to share his expertise. He’s part of the ARID LID (low-impact development) coalition in the middle Rio Grande watershed. He also contributed to the Nature Conservancy’s “Climate-Ready Trees for Albuquerque” project.
“Trees are crucial to regulating temperatures in a heat island, but people need to know what to plant,” he says. “It’s important that we have a diverse tree canopy.”
In the ‘90s, when water was at a surplus, Southwesterners were planting Eastern trees, which not only exacerbated allergies but later died, leaving no canopy at all. Today, the city is offering incentives for residents and businesses to plant more native, drought-tolerant trees.
The city of Albuquerque and companies like WaterWise are a model to others on how to cut water consumption even as the population grows.

“I’ve been fortunate to be around a long time,” Hunter says. “We’re booked out with landscaping projects through the spring, and clients are more concerned with saving water and have seen a lot of good examples.”

As WaterWise projects indicate, with smart water solutions, clients can enjoy colorful palettes with native plants and plenty of back yard wildlife.

WaterWise Landcapes, Inc.
Email: hunter@waterwiselandscapesnm.com
Phone: (505) 344-7508 www.waterwiselandscapesnm.com

Jessica Elrod earned her bachelor’s degree in fine arts and had her sights on a fashion career, but her family roots in landscaping were just too strong.
Her father, Brad Allen, started Natural Landscaping in 1979 in Fresno, California, where she grew up helping the family business. Even while working other jobs and running her own business, Jessica continued to assist her father from time to time. But four years ago, she decided to make a big career change.
“After having children and seeing my parents ready to slow down, the Lord had a different plan for me,” she says.
Jessica now works full-time for Natural Landscaping as a landscape designer. She puts her trained eye and crisp design skills to use creating beautiful and functional landscapes while attracting a new generation of clients. “When planning their landscapes, younger clients really want a visual, so we do a lot with social media and video as well as using hand drawings and 3D Structure Studios,” she explains.
Natural Landscaping is a licensed California state contractor, handling design through installation. “We work in the entire Central Valley area, which has given us experience in a variety of terrains,” says Jessica.


The company completed a project for the Freeman family in November. The couple had recently built a home on a vacant lot in a brand-new subdivision with very few trees.
Jessica saw the property as a blank canvas with lots of opportunities for creativity.
“Before I begin a project, I give my clients a quiz,” says Jessica. “A lot of times they don’t know what they want—modern or traditional, straight lines or curved edges, formal or informal. So I show them a lot of images and they point out what they like.”
The Freemans love spending time outdoors and wanted a seating area, an outdoor fireplace, a swimming pool and room for plenty of plants. Mr. Freeman collects bonsai plants, so outside the garden shed Natural Landscaping created a special place to display them. Mrs. Freeman enjoys gardening, so the team created a raised bed, complete with a custom trellis, for her tomatoes. Behind the shed are fruit trees, including lime, orange and kumquat.
“The biggest challenge is that the lot is on solid rock,” says Jessica. “We had to use a jackhammer for every single plant.”
Location: Fresno, California Build Time 7 weeks, excluding the pool build Size: Half an acre
But despite the hard work, the finished product looks effortless. Mature, fruitless olive trees grace the property. Lomandra grasses, flowering purple coral bells and variegated Pittosporum soften the hardscapes and the home’s stucco exterior.
“Drought is always an issue here,” Jessica says. “Every job I go to, we need droughtresistant plants, but that doesn’t have to mean only cacti.”
Natural Landscaping uses TigerTurf synthetic grass, which adds lush green spaces without the maintenance or need to water. For the patio, oversized, square concrete pavers were formed on-site. A Duralum patio cover provides shade over one section of the outdoor space on hot days. In the dry beds, Jessica designed a rock garden with smaller two- to four-inch rocks as well as larger Noiya river rock. Beds also contain mini pebble mulch.
“Since we can’t have a lot of colorful
blossoms in our climate, I like to incorporate lots of different textures and points of interest,” she says.
The side of the property slopes, so the team built a retaining wall with precast bullnose that helps prevent erosion as well as creates seating. The wall is finished in an El Dorado stone veneer in orchard cypress ridge. Natural Landscaping built an additional rock wall to create a courtyard as well as an outdoor fireplace in the same stone veneer. “With the fires here in California, you can’t have anything woodburning, so the fireplace is natural gas that ignites with an easy key turn,” says Jessica.



Just steps away from the fireplace, the swimming pool was nearing completion at the time of publication. Jessica’s design
includes Spanish tile along with a raised spa and spillway.
The property is exquisite at night thanks to the lighting design. “California nights are beautiful all the time,” says Jessica. “Outdoor spaces are a big extension of living rooms here.”
Natural Landscaping installed uplighting from FX Luminaire to showcase every tree on the property. Cap lights accentuate the stone wall while providing an ambient glow. Downlighting illuminates the pathways throughout the garden and at the front entrance of the home.
After navigating the company through the pandemic as well as area wildfires, Jessica has come out with more confidence that she’s exactly where she needs to be.

“It was a little daunting at first,” she says. “Growing up, I thought landscaping was a man’s world, but I’ve been pleasantly surprised. Many of our clients are female, and I make them feel comfortable—we relate to one another.”



I’ve found my place as a woman in this industry and have felt very accepted














The Mount Rainier Integrated Bollard is available in powder-coated black aluminum and features a single cutout that casts soft light ideal for pathways, walkways and garden accent lighting.




Includes:
· Integrated Light Source 6W, 400 Lumen, Frosted Mini Beam in 3,000
· LightingShrink Professional Crimp and Heat Shrink Cable Connector
· Stainless Steel Impaler Stake
The Mount Rainier carries a 3-year repair or replacement warranty and a lamp life of 30,000 hours.
For more information, visit brillianceled.com/mount-rainier or contact your local Brilliance representative listed on brillianceled.com/contact.
Microsized yet mighty, this lineup of easy to conceal FLEX Niche fixtures casts high-powered, focused lighting without ever revealing their location. The 100 percent solid brass construction protects the inner electronics. 3W LED modules deliver an impressive output, while remaining efficiently cool during operation. Meticulously crafted to fire high-powered lighting from fixtures that could fit in the palm of your hand, they’re built to be versatile, and the modular, interchangeable parts enable customized assembly needed for the job. The most popular combinations are conveniently available as ready-to-install, preassembled fixture kits. Select from FLEX Niche Bullet Light, FLEX Niche Uplight (6" & 18"), FLEX Niche Director Light (2" & 6"), FLEX Niche Curved Path Light, FLEX Niche Tree Light with Uniball Mount, FLEX Niche Landscape Washlight (2" & 6") and FLEX Niche Director Washlight. coastalsource.com
For the environmental revitalization, restoration and renaturalization of two Summit Metro Parks destinations in Akron, Ohio, Summit Lake Nature Center and the historic Valley View Barn, Dauer’s Silhouette Collection of lighting bollards incorporates the leaf logo, the emblem of the state’s second-oldest park district, into the landscape lighting design. Working in collaboration, Summit Metro Parks’ in-house landscape architect team and Dauer Manufacturing designed the day-into-evening effects to bring in low lighting that creates a subtle, yet distinguishable, brand expression. Celebrating its 100-year anniversary this year, Summit Metro Parks redesigned the landscape lighting for both Summit Lake Nature Center and Valley View Barn as part of a larger beautification project to restore natural habitats during the park district’s centennial. dauermanufacturing.com




EmeryAllen is a privately held company located in Charleston, South Carolina. On a day-to-day basis, they rely on 30-plus years of experience in the lighting industry to bring some of the most technologically proficient and well-rounded lines of lighting products to the market. Over those 30 years, they have established worldwide product development, manufacturing and distribution relationships, which have translated into the highest quality lighting products for customers at the perfect value.
EmeryAllen aims to provide customers with not only a collection of exceptional products, but also assistance in selection and aid in any support for the lifetime of the bulb. Whether you are looking to bring warmth and light to a small apartment or illuminate an entire office park, they’ve got you covered!
www.emeryallen.com
“The Edging Experts” has produced commercialgrade, 100 percent recycled paver restraint, landscape edging and specialty edging products since 1978.
Constructed of strong, durable, flexible 100% recycled materials, Oly-Ola’s 12 different restraint/edging styles include:
• “L”-shaped paver restraints in a range of heights
• Round-top and low-profile landscape edgings


• 6" and 4" high “L”-shaped restraints for green roof, permeable paver and aggregate stone installations

Made in the USA, Oly-Ola’s edgings have a robust and comprehensive product guarantee. Customers can expect hassle-free shipping and products being sold exclusively through independent landscape supply or garden centers, landscape contractors and landscape architects. www.olyola.com
Colmet® continues to innovate when it comes to steel landscape edging—65 years after its first patent was filed. With new Seamless Lock technology, Colmet’s new steel edging offers easy installation, sturdier stakes that don’t pop up and a flush front. Connect all your edging and form the bed all at one time before driving it into the ground. Coming this spring to retailers and distributors in eight foot and 10 foot lengths. Available in 14 gauge to 1/8-inch thicknesses and powder coated for extra durability. www.colmet.com


Introducing our new and improved steel edging system. The system interlocks with a seamless attachment hinge, making it an invisible connection within the system. Perfectly designed for structural intergration around your home and garden. Even more perfect for your installation with our Geo Ground Grid, Hexpave Grid or Easypave Grid, to hold all of your gravel right into place.
Designed with the highest end 316 Stainless Steel, to never rust or corrode over time. Comes with three mounting spikes per unit ordered. Each unit is three feet in length. www.standartpark-usa.com
VertEdge was designed with over 35 years of knowledge in the flooring and artificial grass industry behind this revolutionary multi-use system. It will provide a safer, stronger and smarter perimeter finish to an artificial lawn installation. There is nothing else in production worldwide that is similar to VertEdge in its design or application.
It can be cut to curve around sidewalks or stones while still letting water through. When installed correctly with the Exposed Ramp install method it is ADA compliant. If you are looking for a sleek, hidden and crowned appearance, we recommend our Covered Tucked method. Either way 100 percent of your perimeter is secured with no exposed nails.

www.vertedge.com
Introduces a revolutionary system for holding permeable paver systems (PICP) together. It allows the use of Steve’s original industry standard spiked edge restraints with steel spikes anchor or his new GeoTension grid anchoring system StrypRAIL or BOTH! This commercial and residential project tested and proven system provides the most secure edge restraint in the paver industry. Paver industry focus on providing BMPs (Best Management Practices) for permeable pavers help grow market share and acceptance as Fortress leads the way to build the pavements properly.
www.fortressedging.com



















Ihave claimed for quite some time that landscape lighting design is an art form. While outsiders may consider it a common trade, landscape lighting is an untapped discipline—it requires an understanding of the principles of composition as well as human psychology.



So how do we raise the bar? I believe there are three ways. First, we must take the subjective nature of this art form and make it more objective. Second, we need to understand the principles of composition. And, lastly, we can implement those principles to ensure a consistent measure of good lighting design.
A subjective design means that the effect and beauty are in the eyes of the beholder. However, this is a very loose and ineffective means to judge what we provide to customers. Any lighting can be considered good, even if it’s poor. An objective measure allows one to apply concepts, standards or practices that are accepted by experienced professionals.
level of expectation, but it would allow the lighting industry to have a means to accurately judge works. This would be a huge benefit for awards contests and peer recognition. No longer would the profession be judged in bias by opinion over an understood and measured set of principles.
If we continue to raise the standard, our work will only get better. Not only will our clients notice the difference, our entire industry will.
Our work begins with the creative process of applying light and shadow within landscapes and natural environments. We want to encourage a positive feeling or experience to the end user; but before we can accomplish that, we need a defining measure for what is considered good or bad. Much of our trade is left to define their own measures, and we must change this if we are to advance.
The landscape lighting profession can utilize composition as understood by the art world as a measure to objectively study a lighting design. The six principles of composition include balance, contrast, emphasis, pattern and rhythm, unity and movement. Every landscape lighting design can apply these basic rules and determine whether a design might be considered good or not good.

Not only would this practice set a higher
Mark Carlson is the founder of the Experiential Landscape Lighting Initiative (ELLI), an educational resource dedicated to the landscape lighting profession. He has 22 years of experience as a landscape lighting designer. Carlson is currently performing studies on the psychology of light and nature to provide therapeutic relief in human health. He is also the owner of Avalon Lighting Design.
www.landscapelightinginitiative.org
With an increased demand for zero-emission outdoor power equipment, innovative and affordable charging solutions are needed to power the gas-to-battery movement, according to Richard Ogawa of TOWA Industries, a manufacturer of zero-emission solutions in the outdoor power equipment industry.
Before starting TOWA, he supplied outdoor power equipment to universities and Silicon Valley companies wanting to create emission-free campuses before green technology was mainstream. There were few options available, so he founded TOWA Industries to address their need for mobile power solutions to help charge their battery-powered equipment.
There was a critical need for charging infrastructure development and making the migration from gas to battery equipment safe and affordable, says Richard. The costs associated with switching to batteryoperated equipment can create a barrier for businesses that cannot afford to replace all their equipment.
In response to the problem, TOWA created a brand-agnostic conversion kit that allows companies to convert their existing two-cycle gas-powered equipment to battery easily and quickly. The kit can be used with any brand of equipment.
They also developed a Power Distributor Manager (PDM) appliance to address the
need for more charging infrastructure. The technology automatically manages electrical current and flow, ensuring companies never blow a circuit. It can also switch power from battery units that are fully charged to ones needing to be charged without having to change the units manually. The PDM is also scalable. If a company has multiple batteries that need to be charged simultaneously, multiple PDM appliances can be stacked or mounted.
When a national commercial landscaping company began transitioning its services to battery-powered alternatives as part of its strategy to reduce carbon emissions, TOWA’s PDM solution was a fit for their power supply needs. While piloting their

electrification program, it became evident that the existing power supply at their branches would not be sufficient to charge the required number of batteries (100-plus) for teams to effectively service client properties. In need of a scalable solution to efficiently increase their charging capabilities without having to hire an electrician or labor to manage the manual rotation of batteries, they implemented TOWA’s PDM charging solutions to leverage its existing power supply and continue to employ solutions to help reach their goal of becoming carbon neutral.

Recently, local and state governments have passed laws banning combustionengine power equipment. In January 2021, the city of Oakland passed an ordinance that required their landscape division to make mandatory changes. By utilizing TOWA Tools’ products, the city successfully converted its existing commercial equipment, bringing them into compliance and saving an estimated $30,000. In 2021, the state of California signed Assembly Bill 1346, which states it will prohibit the sale of small, off-road

engines by 2024 or as soon as feasible. This means that even consumers who were not looking to shift to green technology will soon be required to do so.
During the pandemic, people around the country began working remotely from home. Many homeowners’ associations restricted the hours that landscaping companies could work due to the noise associated with gas-powered equipment. Their workday was inevitably pushed to a later time, which decreased productivity and hurt the bottom line. By utilizing electric-power technology, companies could adapt to unprecedented challenges while providing dependable customer service.
Although the move from gas to battery is undeniably a positive one, Richard shares that several components are important for a successful transition, with the most critical elements being “battery equipment technology [with] gas-like performance, a robust and scalable charging infrastructure, and [local, state and national] advocacy support.”
Major supply chain issues and delays limit the availability of some materials,
including those needed to develop battery technology. In addition to manufacturing hurdles, the lack of large-scale charging infrastructure is also a cause for concern. Companies and local/state governments need to address how they will charge their large equipment inventory without negatively impacting their business.
Educating the public and government leaders on successfully making the transition is crucial in pursuing an emission-free world. Everyone, from policymakers to homeowners, should learn strategies to address the long-term effects of using battery-powered equipment. This includes developing a plan to dispose of batteries when they reach the end of their life.
“There’s no one addressing the recyclability and repurposing of all these [battery] cells. They are coming to us, and we have no idea what to do with them,” Richard says.
This is the most significant aspect missing from the existing transition strategy, and Richard hopes to influence positive change in that area. An integral part of the gas-to-battery movement is education and advocacy to help create a cleaner, more sustainable future for generations to come.
Marketing Manager for TOWA Industries Inc. (TOWA Tools)
Email: karissa.ogawa@towatools.com Phone: (650) 204–0019 www.towatools.com
 Jay Worth Explains Why Hiring Costs Money
Jay Worth Explains Why Hiring Costs Money
As you’re looking at ways to save time and money with your landscaping business, one area that’s often overlooked is employee retention.
According to research from the Society of Human Resource Management (SHRM), it can take as much as three times the offered salary to recruit a new employee. This means if you’re offering a position that’s going to pay $45,000 annually, it can cost your company up to $135,000 to staff that position.
That figure doesn’t include training your new hire. Research done by payroll firm ADP showed the average to train a new employee across all industries was $1,886 in 2017. It’s more expensive when you’re talking about lower-wage, hourly employees. The Houston Chronicle’s Small Business section cites research showing it can take over $9,400 to train a replacement for a lower-wage, hourly employee.
As I mentioned, keeping the employees you’ve got is a fantastic starting point. There are several factors that contribute to employee retention. This isn’t an exhaustive list, but these items are critical to successful retention.
One study showed that 60 percent of employees who have been with your company for less than one year value the opportunity to advance more than they value training.
Stated another way, these employees would rather you show them how to get ahead than invest time and money helping them become better professionals.
I would suggest the two are not exclusive. You can create a pathway to advance through the organization with some intentional focus. Start with your frontline workers and create a list of measurable, achievable goals that any person in that role would need to accomplish in order to
get promoted within their department. Once you’ve done that, keep moving up the organizational ladder all the way to CEO.
Showing your people how to advance will keep the most ambitious people in your workforce engaged.
I cannot oversell the importance of this point. If you need research, the Harvard Business Review states that companies with positive work cultures and highly engaged employees “enjoyed 100% more job applications.”
be setting yourself up for an unhealthy working culture.
Truly, this should simply be called “life balance.” A person’s job, however invested they are, is only one aspect of their existence.
Creating, defining and communicating your company’s core values will do several things for you.

It tells your current and future employees what your company stands for and what values are most central to how you run the business.
It also helps people who are not a good fit “self-eject” from the company. These are people who would have created problems of one sort or another down the road, so this isn’t always a loss.
Lastly, it keeps people who really believe in what you’re doing engaged. When they’ve got a purpose or a mission to fulfill, they’ll stay with your company longer and work harder while they’re there.
If you need anecdotal evidence that this is true, ask yourself a very hard question: Why aren’t your current employees referring people to come work for you? It’s not because they don’t want these massive “referral bonuses” that have become popular. It’s because they aren’t willing to sacrifice those relationships for that amount of money.
Healthy company culture is defined by trust, open and consistent communication and expectations being clearly stated. People are tasked with work and then given the tools and resources needed to succeed in those tasks. Their time outside of work is respected, and any asks above and beyond the normal working hours are either communicated weeks in advance or asked of employees rather than expected.
Anything short of these basics, and you’ll
If you’ve recruited well, you’ve hired well-rounded, driven people. Those people often have commitments outside of work to consider. They’ve got families to take care of, Little League to coach and food pantries at which they volunteer.
You must give them time for the other things that energize them so they can give their best when they come to work. That means not working them an insane amount of hours and justifying it by saying “well, you get the winter off,” especially if you offer snow removal services.
Give people the time they need to live fulfilled lives, and you’ll find they’re more present and productive while at work. Think about onboarding in two separate
“Give people the time they need to live fulfilled lives, and you’ll find they’re more present and productive while at work. “
“buckets.” There is onboarding that every employee needs (regardless of their role or title). There is also information that needs to be communicated to a new hire that is specific to their job.
Ask a friend who doesn’t know anything about your business to help you with this. Pretend they’re new and you’ve hired them for an open position. What things do you need to communicate with them? These might include:
• Where to park
• How to clock in and out
• Any software logins they’ll need to use on a regular basis
• A review of benefits and the deadline to make elections
• Uniforms or dress code
• A review of the company’s core values, with examples of how to implement these on a day-to-day basis
After that, you need to provide individuals with training based on their roles. How you want functions performed (hand edging, hand pruning, mulching, etc.) and how to use any equipment you’re expecting them to use.
A great way to do this is to start with the “everyone” training and then give one-on-one
or small group training to people based on their job function.
Ignoring onboarding is a huge mistake. When you don’t set your expectations out clearly from the very beginning, you’re setting your team up for failure. If they know what you expect from day one, minute one, you’ll be in a much stronger position as a company.
Green Industry work carries some of the most significant risks of injury and death. In 2016, almost 60 percent of safety occurrences for arborists were fatal. Between 2001 and 2017, research done by the National Institute for Occupatioinal Safety and Health showed that almost one in five worker’s compensation claims in the landscape industry were “serious injuries.”
We cannot reasonably expect people to work in a dangerous industry without compensating them well.
You should be offering your people benefits. Many payroll services will allow you to buy in at their group rates rather than purchasing them on your own. Leverage their group discounts to offer your employees protection. The Massachusetts Institute of Technology (MIT) compiled a Living Wage Calculator. This shows what it takes to live a normal life in

every state, county and metro area around the country. Reference this when setting wages for your frontline workers, and use it as a baseline for considering what to pay your managers and C-suite hires.
“Getting your house in order” is a great way to ensure you save time and money. You’ll dramatically reduce costs in recruiting and training and add consistency to your business.
Scan the QR code below for more information:

Marketing Manager www.singleops.com

Landscapers often find themselves with little room, little time and lots to do. Most leverage the versatility of a skid-steer as a means of expanding their service offerings without paying for standalone equipment. Skid-steer-mounted stump grinders are compact, quieter and less expensive than a standalone grinder while offering an extremely quick ROI. Able to disintegrate stumps up to 10” below grade while achieving a 5” cut per pass, the Skid Pro Stump Grinder has been proving for over 10 years why it’s the best in the industry with a 2-year warranty and thousands sold. See for yourself at www.skidpro.com.
Removing stumps couldn’t be simpler or more cost-effective!
The DR PRO XLSP is a self-contained, selfpropelled machine that employs eight carbide tungsten-tipped teeth to grind away hardwood stumps with ease. Once positioned, the operator simply locks one wheel, engages the cutting head and pivots easily from side to side, shaving off an inch or more with each pass. A hefty OHV engine (11.7 HP) provides plenty of muscle and with its compact footprint (51”L x 29”W), the DR takes up very little space on a trailer. See the full line at www.DRpower.com.
The Toro® STX-38 Stump Grinder is built for outstanding durability in the toughest conditions. Fully hydraulic operation means no chance of expensive belts breaking or slipping and no tension adjustments.

The Intelli-Sweep® feature automatically slows the sweep speed of the cutting head based on the load of the wheel, so heavy cutting loads won’t bog down the engine or your progress. And with easy-to-use, TX-style controls and tracks for maneuverability and stability, the STX-38 is extremely operator-friendly. The STX38’s electronic fuel injection engine provides less maintenance, easier starting and improved performance. Best of all, ground speeds of 4.5 mph allow you to spend more time grinding and less time transporting the machine—for greater productivity. For more information, please visit www.toro.com.










Natural stone pavers maximize a project owner’s investment due to their beauty, durability and longevity. They are a popular hardscaping choice because they can withstand the elements in various environments. Natural stone is the original building material of the Egyptian and Greek monuments that are still standing today.
Natural stone is cost-effective when it comes to maintenance. It is also environmentally friendly because the sourcing process has less impact than manufacturing, and natural stone can be reused. There is also versatility in the aesthetics. Stone can be rustic (riven surface) or contemporary (honed) and can be used in endless shapes and designs.

We started discussing how to properly
install paving in the July/August 2022 issue on pages 39-41. Installation is one step in ensuring that pavers will last to their full potential, but proper maintenance will help keep them functional and beautiful for the long haul. The secret to ensuring the longevity of pavers is remembering that maintenance considerations start with the initial design and intent of the space.
Handing over hardscaping maintenance may seem straightforward, but it gets more complicated when natural stone sees a variance in weather. A stone that might be appropriate in south Texas or southern California for a paving application is not necessarily a material that would be appropriate in Chicago or St. Louis, where there is a high number of freeze-thaw cycles. The climate factor is important, as selecting the right materials with the

appropriate physical properties to withstand the elements will be critical.
Microclimates, where a small area differs from the surrounding climate, are also an important consideration. Microclimates are defined by the moisture, temperature and winds of the atmosphere near the ground, vegetation and soil, in addition to the latitude, elevation and season.
When a stone’s physical properties take a
backseat to design and aesthetics, proper maintenance can be an impossible goal, affecting the project’s overall quality. Knowing the physical properties before selecting a stone will help ensure your structure looks as impressive in the coming decades as it does on day one.
Each type of stone has specifications that may or may not work with the application. For instance, limestone, marble, granite and travertine pavers perform well in low-traffic and warm climates that do not

experience freezes and thaws, so longterm maintenance is minimal. It also matters if the paving regularly has water on it and the region you are in—or how easily the stone is worn or smoothed by foot traffic.


Using those same materials in an environment with harsh weather makes them susceptible to decomposition if exposed to ice salt acids. Silica-based materials are less absorbent and will withstand those conditions with minimal impact.
One key to understanding natural stone’s physical properties is working with a natural stone supplier who can provide guidance early in the design process. A design team may have a specific aesthetic goal in mind, but you should consider if the choices will perform in the environment. Understanding each stone’s properties will ensure the right stone has been selected for the project and bolster the architect’s case for their choice of stone.
The American Society for Testing and Materials International (ASTM) created two testing methods to determine a stone’s physical properties by absorption rate and abrasion resistance to help decide if the material will work in the environment. ASTM develops standards
for materials to provide a consistent and realistic set of testing procedures for stone products and is recommended as a first step in deciding on a stone type.
Even with the right stone, if it has not been correctly installed, there will be issues. However, sometimes the issue comes up as a maintenance problem, even though it was probably due to a shortcut during installation.
Consult with experienced stone setters for specific nuances, such as proper air gaps in vertical installations like retaining walls. Air gaps can eliminate the effect of water moving through the soil and leaving behind salts on the natural stone.
In exterior locations, natural stone does not need a sealer. Sealers cannot allow a

material used in the wrong location to survive—it is more appropriate for other types of paving. Our best advice is to leave the stone natural and not apply a sealer, as this can compound other issues. If a sealer is used, it can wear off over time, leaving the stone full of spots.
Natural stone pavers are easy to maintain if the right materials are used—and the installation is done correctly. General maintenance can be scheduled once a year. This is an excellent time to check for cracks or broken seals that can prevent damage from dirt and othe environmental elements.
Water is the ideal way to clean and remove debris and restore materials. A light pressure washing annually goes a long way in maintaining your surface. Pay special attention to joints that can be
impacted over time. Building elements, like joint compounds, will need to be recaulked every four to eight years because they naturally shrink away, and the gaps allow water in. Mortar, on the other hand, lasts longer unless it is used in an area with a colder climate.
The design, material selection and installation process should start with the end in mind. Maintenance may be the last step in preserving a hardscaping project, but it should not be the last thing to consider.

Phone: (830) 730–6765 Email: bkock@coldspringusa.com www.coldspringusa.com

